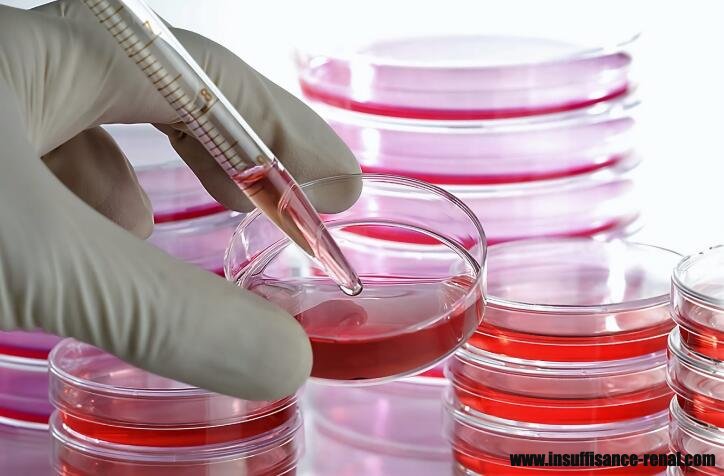
Est-thérapie de cellules souches Pour néphropathie à IGA

Est-thérapie de cellules souches Pour néphropathie à IGA
J'ai étape 3 de néphropathie à IgA. Est- cellules souches un remède? J'ai du sang et de protéines dans l'urine. Therapie de cellules souches est une nouvelle thérapie pour traiter les maladies du rein et peut apporter un espoir pour la néphropathie à IGA.
J'ai étape 3 de néphropathie à IgA. Est- cellules souches un remède? J'ai du sang et de protéines dans l'urine. Therapie de cellules souches est une nouvelle thérapie pour traiter les maladies du rein et peut apporter un espoir pour la néphropathie à IGA.
Traitements communs pour la néphropathie à IGA
Les médecins vous donnent habituellement hormone, tripterygium wilfordill crochet, cyclophosphamide et d'autres médicaments occidentaux pour inhiber le jaillissement des anticorps et des immunoglobulines. Cela ne peut se concentrer sur les causes de la maladie primaire, mais ignorer le dégagement de IGA envasement du récepteur et complexe immunitaire. En outre, il peut aussi ne pas améliorer l'ischémie rénale et de l'état d'anoxie. Par conséquent, il ne peut pas réparer les dommages causés efficacement les cellules mésangiales rénales et la membrane de filtration glomérulaire. Ensuite, le taux de filtration glomérulaire ne peut pas revenir à la normale. La néphropathie à IGA retombe souvent dans cet état.
Therapie de cellules souches pour la néphropathie à IGA
Therapie de cellules souches traite Therapie de cellules souches de la racine. Les cellules souches injectées peuvent entrer en lésion rénale directement, et de restaurer efficacement les cellules intrinsèques du rein blessé et produire les cellules qui ont été détruites sévèrement. Les cellules souches semblent avoir les fonctions suivantes:
Réparer les cellules de rein de blessés par stimulation du facteur de croissance cellulaire
Régénérer nouvelles cellules rénales et éventuellement remplacer les cellules rénales nécrotiques la réparation de ce fait et influencer positivement la fonction rénale
Améliorer le fonctionnement de votre système immunitaire, ce qui entraîne une résistance accrue aux agressions de l'environnement extérieur
Reconstruire un meilleur rendement hormonal des reins, avec une augmentation des globules rouges du meilleur équilibre et d'électrolyte.
Therapie de cellules souches est un moyen fondamental pour la néphropathie à IGA. Dans notre hôpital, certains traitements de médecine chinoise comme Micro-médecine chinoise osmothérapie, Bain de pieds , Mai Kang Mélange, soupe médicinales et la thérapie moxibustion combinent souvent avec la thérapie de cellules souches pour traiter les maladies du rein. Si vous voulez en savoir plus d'informations, vous pouvez envoyer un courriel à insuffisance-renal@hotmail.com ou laisser un message ci-dessous directement.
précédent:Comment traiter la maladie polykystique par la maladie traditionnelle chinoise
suivant:Traitement de chinosie traiter de haut niveau créatinine naturellement

